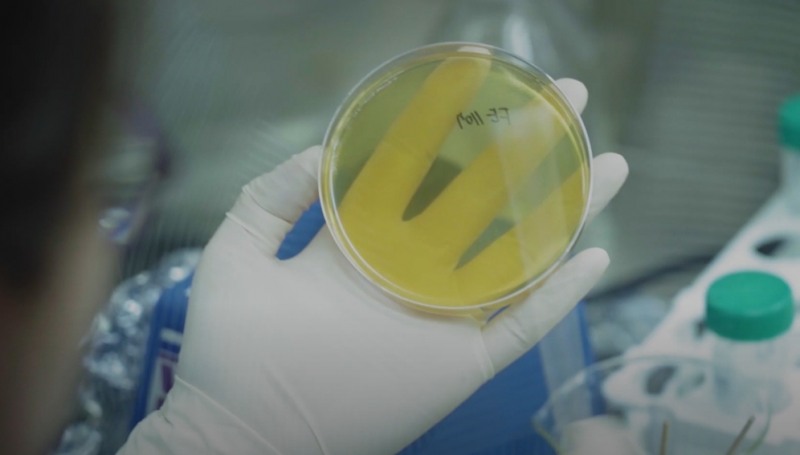
천연물 개별 인정형 원료 탐색 중인 녹십자웰빙의 연구원.(사진=더넥스트뉴스)

'GCWB204' 2상 본 임상 피험자 투약 마무리 단계
건강한 100세 시대 위해 PNT솔루션 강화
향후 개별 인정형 원료 건기식 개발 목표
"PNT솔루션을 통해 각각 개개인에 맞는 가장 적합한 치료를 제공함으로써 헬스케어 부분에 있어서 선두로 나갈 것이다. 이를 바탕으로 건강한 100세 시대를 열어가고 싶다."23일 오전 <더넥스트뉴스>가 방문한 녹십자웰빙은 암악액질 치료제인 'GCWB204'의 임상 2상 피험자 투약 마무리 작업에 분주했다. 녹십자웰빙은 지난 7월 암 환자 110명을 대상 유럽에서 진행한 탐색적 임상(2a상)을 마쳤다. 현재는 본 임상(2b상)을 진행하기 위한 피험자 1200명을 모집해 투약을 진행하고 있다.
유영혁 녹십자웰빙 대표이사는 "빠르면 이번 주, 늦어도 다음 주면 임상 2b상의 피험자 투약이 마무리될 예정"이라며 "결과가 좋으면 이를 바탕으로 'GCWB204'의 유럽 쪽 기술이전을 진행할 계획"이라고 전했다.
'GCWB204'는 녹십자웰빙이 인삼에서 추출한 진세노사이드를 주 성분으로 한 천연 경구용 치료제이다. 주 대상 질병은 암악액질이며 이 외에도 복수의 암 치료제 후보물질로 등록돼 있다. 지난 7월 독일과 우크라이나, 조지아의 18개 의료기관에서 임상 2a에서 암악액질 치료제로써의 가능성을 확인했다.
암악액질이란 식사 후 영양소가 정상적으로 몸에 흡수되지 못하는 현상을 말한다. 암 종양이 탄수화물과 단백질, 지방을 대신 소모해 정상적인 식사를 하더라도 환자의 상태가 지속적으로 악화된다. 암 환자들의 체중이 감소하고 운동 장애, 영양 장애, 빈혈 등을 겪는 이유가 바로 이 암악액질 때문이다. 현재까지 개발된 암악액질 치료제는 전무하다.
유 대표는 "탐색적 임상에서 'GCWB204'의 계단 오르기와 같은 주 평가변수는 통계적 유의성을 확보하지 못했는데 안전성과 삶의 질 개선 등 추가 평가변수에서 유의한 개선을 보였다"며 "본 임상에서는 신체기능 저하 등 주 평가변수 유의성 확보에 최선의 노력을 다 할 예정"이라고 설명했다.
'GCWB204'는 향후 녹십자웰빙의 주력 사업인 PNT솔루션(개인 맞춤형 영양치료제)의 핵심 치료제이다. PNT솔루션이란 '건강한 100세 시대'를 준비하기 위한 녹십자웰빙의 개인 맞춤형 건강관리 프로그램이다.
기존 건강관리는 보편적인 치료·예방 방식을 택해왔다. 개개인의 생활 습관과 환경이 다름에도 같은 예방제와 치료제를 투약하는 식이다. 반면 녹십자웰빙의 PNT솔루션은 개인의 건강상태를 검진해 각자에 맞춰진 치료·예방 방식을 제공한다.
유 대표는 "사람마다 각자 영양소가 과한 부분이 있고 부족한 부분이 있다. PNT솔루션은 과한 부분들을 줄여주고 부족한 부분들은 채워 넣어주는 치료 방식"이라며 "고령화 시대에 사람들의 삶의 질을 높이는 것이 녹십자 그룹에서 우리가 맡은 역할"이라고 말했다.
녹십자웰빙의 다음 목표는 천연물 개별 인정형 원료를 바탕으로 한 건강기능식품을 개발하는 것이다. 이를 위해 최근 경기도 성남 도담빌딩 7층에 위치한 본사를 9층까지 확장했다. 연구원들이 9층에서 연구개발에만 전념할 수 있도록 사무실을 분리했다.
유 대표는 "십여 년 가까이 신약 개발에 전념해왔다. 연구개발에서 특히 지속적으로 성장과 이익을 창출해 왔다. 이러한 경험을 바탕으로 글로벌 신약 개발도 도전했다"며 "천연물을 기반으로 한 암악액질 치료제를 개발해 글로벌 제약회사로 성장하고 이후에 개별 인정형 소재들을 중·장기적으로 개발해 PNT솔루션을 강화할 계획"이라고 포부를 전했다.
백청운 더넥스트뉴스 기자 cccwww07@thenext-news.com